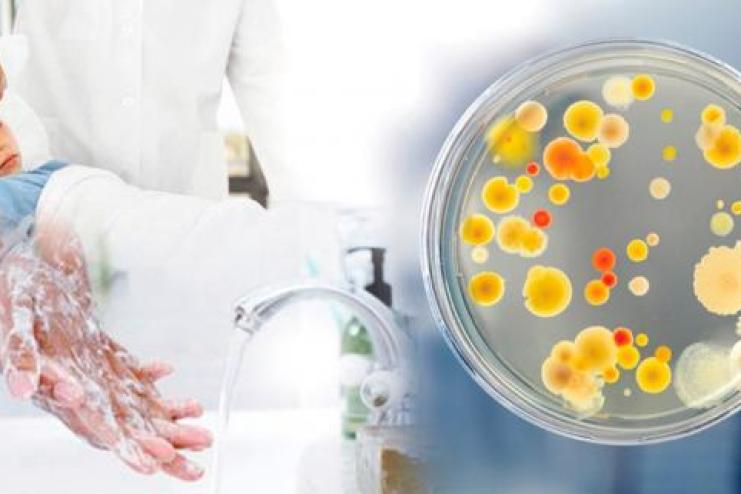

Гострі кишкові інфекції та кашлюк: що відомо про епідемічну ситуацію в Одеській області
За минулий тиждень на Одещині захворюваність на гострі кишкові інфекції, у порівнянні з попереднім тижнем, зросла на 21%, у тому числі серед дорослого населення – на 39%, серед дитячого – на 10%.
Про це повідомляє «Кут огляду» з посиланням на Одеський обласний центр контролю та профiлактики хвороб.
Зареєстровано 1 випадок підозри на кір у м.Одесі. Захворіла дитина 7 років, організована, щеплена проти кору згідно з календарем профілактичних щеплень .
На звітному тижні зареєстровано 47 випадків підозри на кашлюк, що у 2,7 рази більше ніж на попередньому тижні (17 випадків). Випадки зареєстровані в Ізмаїльському районі (20 випадків), Одеському (15), Болградському (6), Подільському (5) та Роздільнянському (1). Захворюваність реєструвалась спорадичними випадками.
Захворюваність на грип та гострі респіраторні вірусні інфекції (ГРВІ) відповідала сезонному рівню.
Захворюваність на COVID-19 зросла на 6 випадків (22 проти 16). Серед захворілих, як і зазвичай, переважало доросле населення (до 88%). Важких форм перебігу захворювання та летальних випадків не зареєстровано.
Слідуйте за нами:
✅ у facebook (та запроси друзів!)
✅ у нашому Telegram-каналі
✅ в Instagram